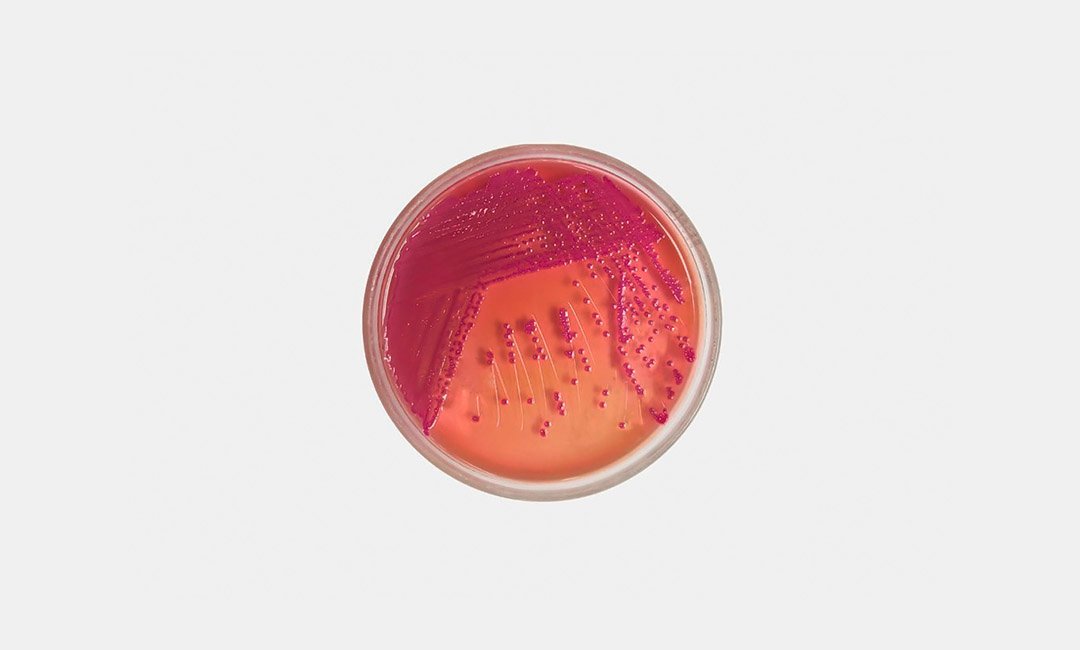

1. Нарушение кишечной флоры
Весь наш иммунитет зависит от желудка, так что если в нем происходит дисбаланс, это влияет на все твое тело. Внутри твоего кишечника могут начать размножаться вредные бактерии, что способствует вздутию живота, увеличению веса и замедлению пищеварения. На это также влияет то, что ты потребляешь мало клетчатки, обезвожена, принимаешь какие-то лекарства или просто питаешься не самой здоровой едой. Чтобы справиться с проблемой, ты можешь использовать пробиотики, а также обратиться к гастроэнтерологу за консультацией.
2. Прием противозачаточных
Противозачаточные средства могут вызывать дополнительную задержку жидкости в организме, что также приводит к нарушению твоего метаболизма. Специалисты клиники Mayo, утверждают, что организму требуется несколько циклов для того, чтобы приспособиться под препарат, так что стоит быть терпеливой, если ты совсем недавно начала принимать таблетки. В то же время, если у тебя есть и другие симптомы, ты можешь поговорить со своим гинекологом о замене препарата на другой метод контрацепции.
3. Заболевания щитовидной железы
Внезапное увеличение веса — распространенный симптом при нарушении работы щитовидной железы, например, гипотериозе или болезни Хасимото. Отек шеи, усталость, замедленный метаболизм, скачущая температура — все это может быть очень вредно для твоего здоровья, так что стоит немедленно обратиться за консультацией к эндокринологу.
4. Депрессия
Депрессия может вызывать нарушения метаболизма и изменения в аппетите, что также приводит к увеличению веса. Все дело в росте кортизола — гормона стресса, который усиливает процесс образования глюкозы через распад мышц. Как результат: твои мышцы разрушаются и начинает образовываться висцеральный жир. Понять, действительно ли у тебя есть депрессивный синдром, не очень сложно, и если ты заметила, что твое настроение на протяжении долгого времени остается плохим, имеет смысл обратиться к специалисту.
5. Нехватка питательных веществ
Если твой организм плохо усваивает питательные вещества или ты в целом ешь несбалансированную еду, это также может нарушить твой метаболизм. Например, витамины A, D, E и K — жирорастворимы, и их стоит потреблять вместе со здоровыми жирами. Добавь в свои обычные блюда несколько продуктов, которые их содержат: кусочки авокадо, лосося, оливкового масла и орехи.
6. Нарушение графика

В случае, когда ты недавно переехала, поменяла график работы или начала ложиться абсолютно в другое время, это также может ухудшить твои циклы сна и вызвать повышение веса. Чем меньше ты спишь — тем хуже выделяется лептин, подавляющий аппетит. Кроме того, ты наверняка начнешь прилагать меньше усилий на то, чтобы приготовить здоровую еду, и двигаться чуть меньше — а это все влияет на твой метаболизм.
7. Резистентность к инсулину
Инсулинорезистентность чаще всего становится результатом хронического воспаления. В этом состоянии жировые клетки растут и вытягивают иммунные, что усиливает противовоспалительные сигналы. Чтобы понять, столкнулась ли ты с чем-то подобным, попробуй отказаться от любых продуктов, которые могут вызывать микровоспаления в организме, в особенности от обработанной пищи.
8. Чрезмерные тренировки
Если ты занимаешься регулярно, то чувствуешь, как тренировки повышают уровень эндорфинов и делают тебя счастливее и продуктивнее. Если же твоих занятий будет слишком много, это может привести к накоплению жира в организме, а также росту кортизола. Особенно это касается силовых тренировок, в которых высокий риск микроразрыва мышц и задержки жидкости.
9. Дисбаланс электролитов

Когда ты забываешь пить достаточно жидкости в течение дня или ешь слишком много соленой пищи, это может приводить к задержке воды в организме и даже вздутию живота. Исправить этот дисбаланс достаточно просто, так что если ты думаешь, что твой лишний вес является результатом обезвоживания, просто выработай полезную привычку регулярно пить воду.
10. Опухоли
А вот если твой лишний вес отложился исключительно на нижней части живота, это может сигнализировать о действительно большой проблеме. Иногда это может свидетельствовать об опухоли, например раке яичников. Чтобы исключить подобные диагнозы, тебе стоит проконсультироваться с врачом, особенно если ты испытываешь боль в этой области.
















